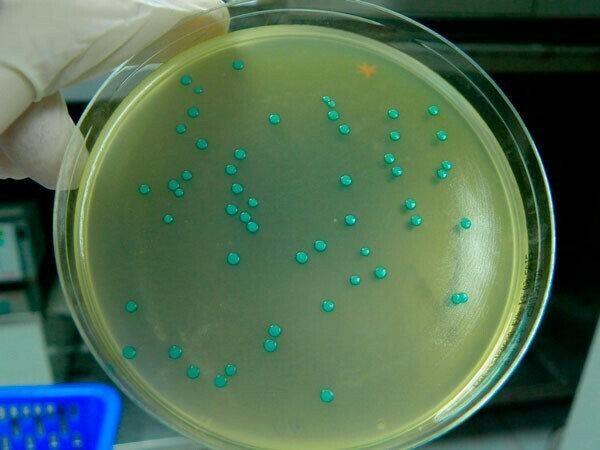
Listeriosis en Europa: los casos más recientes

Responsabilidad Social Empresarial en la industria alimentaria
¿Por qué es importante la responsabilidad social empresarial en la industria alimentaria? Esta es la pregunta que todos nos deberíamos plantear. En el siguiente post vamos a tratar de darle respuesta a este gran interrogante. Hoy en día, los consumidores ya no se conforman en adquirir productos de calidad, sino que, además, buscan productos que sean elaborados por medio de una cadena de valor sostenible. Por la propia naturaleza de la industria alimentaria resulta incuestionable afirmar que nos encontramos ante un sector muy comprometido con la salud y el bienestar del consumidor, además del desarrollo local.
La razón de ser de la industria alimentaria, si recurrimos a una definición general no distaría mucho de proporcionar alimentos y bebidas seguros, saludables y sostenibles a la población, por lo que garantizar la seguridad alimentaria, la mejora de la nutrición, la promoción de hábitos de vida saludable y una producción y consumo sostenibles son parte esencial de la actividad de cualquier empresa del sector. Alinear su estrategia a la de los Objetivos de Desarrollo Sostenible marcados por las Naciones Unidas debe ser su hoja de ruta. El conseguirlo o no, solo dependerá del grado de implicación de todos los eslabones de la cadena de valor, así como de otros agentes vinculados a la industria.
Para tratar de responder a la gran pregunta, ¿Qué papel desempeña Responsabilidad Social Empresarial en la industria alimentaria en la consecución de los ODS? Deberíamos empezar por conocer qué es la Responsabilidad Social Corporativa. La Unión Europea lo define en la «Estrategia renovada de la UE para 2011-2014 sobre la responsabilidad social de las empresas” como “aquella función que maximiza la creación de valor compartido para todos” e “identifica, previene y atenúa las posibles consecuencias adversas” de las compañías en el ejercicio de su actividad. Es decir, ayudar a reconciliar las aspiraciones económicas, sociales y medioambientales de los distintos grupos de interés. Invertir en capital humano, en el entorno y en las relaciones con las partes interesadas.
¿Cómo poner en práctica dicha definición y aplicarla en la política de responsabilidad social empresarial en la industria alimentaria? En primer lugar, realizando un ejercicio de auto convencimiento; creer en ello. Estar convencido de que es algo necesario hoy en día para el bien de la sociedad y del planeta. Y no dejarlo solo plasmado en una bonita memoria. El compromiso debe ser sincero y real. En segundo lugar, se precisa de la implicación tanto de la dirección de la empresa, como de sus distintos grupos de interés: clientes, proveedores, distribuidores y consumidores. Esta iniciativa alcanza y debe implicar a toda la cadena de valor.
Hoy en día no existe ninguna legislación que obligue a ser responsablemente sostenibles, más allá de las distintas herramientas de control que cada empresa quiera adoptar como la ISO 14001 o la ISO 26000. Por lo que estamos ante un compromiso voluntario que no conoce de tamaños ni de sectores productivos. Los recursos hídricos y naturales son finitos,y debemos pensar en la gestión que hacemos de ellos para no hipotecar a las futuras generaciones. Conceptos como la escasez de los recursos naturales, cambio climático, y alimentación segura y saludable, cobran hoy en día un papel importante en las empresas. Ya no solo nos referimos a productos más helthies, si no a las condiciones en las que estos deben salir de la cadena de producción; con todas las garantías de higiene y sanitarias que marca la legislación.
En este sentido podemos encontrar muchos ejemplos de industrias alimentarias que se preocupan por hacer cada día productos más saludables. En la memoria de RSC de Vicky Foods, empresa de alimentación valenciana, encontramos su compromiso de “diversificar sus productos a través de una nutrición saludable e innovadora, adaptada a las necesidades de los consumidores”. De este modo, Vicky Foods trata de posicionarse como uno de los referentes de la alimentación saludable del mercado, desarrollando productos innovadores con mejor perfil nutricional y características más saludables.
Las empresas deben comprometerse con la salud de los consumidores y empleados, fomentando en sus principios, una vida activa y saludable. Que la industria alimentaria aborde estos retos es una cuestión de ética y responsabilidad, que ayuda, además de consolidar la marca, a preservar el planeta. Las memorias de responsabilidad social empresarial en la industria alimentaria se han convertido en tarjetas de presentación de las empresas,y en un vehículo de comunicación externo de primer orden. Son documentos, éticos y transparentes, en los que la empresa tiene la oportunidad de dar a conocer el rol que desempeña en la sociedad y su compromiso con ella a nivel económico, social, de innovación y sostenibilidad.
La industria alimentaria: Un sector estratégico
Según el Informe económico de la Federación de Industrias de Alimentación y Bebidas (FIAB) de 2019, el sector alimentario, como sector estratégico en la economía de España, cerró 2019 con una producción de 119.224 millones de euros, con un VAB de 26.425 M€ y supone un 2 % del PIB nacional, representando el 15% de la industria y generando cerca de 388.000 empleos, el 20,2 % de los puestos de trabajo del país, incluso incrementando 2,1 puntos respecto el año anterior.
La actividad de la industria de alimentación y bebidas tiene una relación única con el medio ambiente, un entorno del que depende para disponer de forma continua y adecuada de materias primas seguras y de alta calidad. Su correcta conservación implica asegurar una producción sostenible a largo plazo y convertirse en un elemento central en su modelo de negocio. Según la FIAB, la industria de alimentación y bebidas de España se encuentra en disposición de avanzar en su estrategia respetando los ODS.
Iniciativas organizadas desde la FIAB como la Plataforma Tecnológica Europea, Food for Life, en la que participa BETELGEUX-CHRISTEYNS, tiene como objetivos desarrollar proyectos de I+D y movilizar el sector agroalimentario en temas de innovación y tecnología, y pone especial énfasis en la salud y en satisfacer las necesidades especificas de los distintos grupos de población.
De la economía lineal a otra más circular
El sistema actual de producción lineal en la industria alimentaria genera distintos problemas medioambientales, sociales y económicos, entre los que se encuentra el desperdicio de comida, la emisión de gases de efecto invernadero y otros derivados de los malos hábitos de alimentación como la obesidad y la malnutrición (La economía circular en la industria alimentaria ,2019). Pero, ¿hasta qué punto una economía circular aplicada al sector alimentario puede aportar soluciones a dichos problemas generando así un sistema más sostenible?
El compromiso de las empresas en el uso y consumo más racional del agua y energía en sus tareas de producción, así como en la reducción de emisiones de gases contaminantes, ayudará a la creación de un mundo mejor. Unido a los cambios notables en la comunicación, da lugar a un consumidor superinformado, que basa sus compras en otros factores más allá de la calidad y el precio de los productos. Se preocupa porque sean sostenibles, ecológicos y producidos por medios justos, apelando a la ética de las empresas.
La economía circular promulga un sistema productivo en el que se mantienen los recursos y los productos el máximo tiempo posible dentro del ciclo económico, minimizándose así los residuos. Así la economía circular apunta un nuevo paradigma en el que la sociedad utiliza y optimiza los recursos, la energía y los residuos, con el fin de ser más sostenibles y conseguir una mayor eficiencia. Hablamos por tanto de repensar y rediseñar los procesos de producción: refabricar, reparar, redistribuir y reducir durante el proceso;, y reutilizar, reciclar y recuperar la energía al finalizar (Concepto Multi “R” de la economía circular, 2019). Según Eurostat, la industria alimentaria es uno de los sectores que más necesita una transformación hacia la economía circular. Un nuevo sistema en el que nada se destruya y todo se transforme respetando los ciclos: producción, consumo y administración de los excedentes de alimentos y productos de desecho.
BETELGEUX-CHRISTEYNS, comprometidos con la sostenibilidad
Esta empresa especializada en la higiene en la industria alimentaria ha presentado recientemente su cuarto informe de RSE’20. Una memoria que recoge los avances de la compañía durante el último año en materia de innovación, sostenibilidad y sociedad, además de servir como instrumento de comunicación con el que da a conocer las acciones y objetivos planteados para el próximo año, que deben llevar a un planeta más sano y limpio y a un mayor compromiso con nuestros agentes sociales.
En este documento se hace un amplio ejercicio de transparencia en el que la empresa se autoevalúa en su búsqueda de la mejora continua, ofreciendo productos y servicios cada vez más eficientes, eficaces y más respetuosos con el medio ambiente. Y todo ello, poniendo en el centro de todas las acciones a nuestros clientes. En este sentido cabe reseñar su servicio de higiene sostenible en el que se puede reducir hasta un 40% los consumos de agua, producto y energía en las tareas de limpieza y desinfección.
El informe RSE de 2020 resume, de una forma concisa y directa, el compromiso de la empresa con su entorno, así como con la comunidad, desde el puro convencimiento de no comprometer las necesidades de las generaciones futuras con un uso excesivo de las materias primas. BETELGEUX–CHRISTEYNS está convencido de que un mundo mejor es posible.
Tras la consecución de la ISO14001 en 2019, y la puesta en marcha de su planta fotovoltaica, la empresa ha decido calcular por segundo año consecutivo su impacto de la huella de carbono. Un indicador que controla la emisión de CO2a la atmósfera y ayuda a diseñar estrategias para que esta se reduzca.
La ejecución del proyecto Objetivo 2025 (O25) es el reto estratégico marcado para el próximo quinquenio. Una hoja de ruta que debe llevar a un crecimiento económico de la empresa a través del uso de nuevas soluciones de higiene cada vez más eficaces, eficientes y sostenibles; el desarrollo internacional de la empresa en LATAM; La digitalización completa de la empresa; la consolidación de la marca CHRISTEYNS en España como marca de higiene en el sector alimentario; una mejora en la gestión de los procesos en la gestión de los procesos a través de un sistema de gestión integrada; mejora del plan de carrera de la plantilla; el uso de envases más sostenibles; la optimización del uso del papel y del plástico en los diferentes departamentos; y el fortalecimiento del compromiso con la sociedad.
Precisamente, este último año, la empresa ha estrechado sus lazos de unión con la sociedad paliando la escasez de productos de hidroalcohólicos en sectores tan importantes como el sanitario, distintos cuerpos de seguridad y ong’s, entre otros. Una solidaridad con la que la empresa ha querido devolverle a la sociedad todo lo mucho que esta nos da.
Atrás quedan acciones que van desde la construcción de un parque público para el disfrute de los vecinos de la localidad donde reside la empresa, hasta distintos cursos de formación de buenas prácticas de higiene entre los escolares.
La empresa es consciente de que no debe utilizar más recursos de los necesarios para no poner en peligro a las futuras generaciones. Es por ello, que ha creado, junto a la Universidad Católica de Valencia, una cátedra para promover el desarrollo económico sostenible y la innovación.
Conclusión
En el siglo XXI debemos ser conscientes del papel de cada sector económico en la cadena de valor, y buscar su responsabilidad y sostenibilidad para mantener funcionando un elemento tan estratégico como la alimentación. La industria alimentaria en España, con un 2 % del PIB, es un sector primordial. Desempeña un papel muy importante en la transformación de la sociedad, influyendo directamente en la salud de los consumidores, que nos debe conducir a modelos cada vez más sostenibles económico y socialmente hablando.
Para ello es importante que el modelo implique a todos los agentes que componen la cadena de valor productiva, independientemente del tamaño de las empresas. Y ahí se centra el reto, en aprovechar las grandes oportunidades del sector, aprovechándose del papel preferente que ocupa, para convertirse en el abanderado de un modelo productivo más sostenible y saludable para una sociedad, conscientes de que los recursos naturales son limitados. Y todo ello pasa en parte por el paso de una economía lineal a una circular.
Sea como fuere, hoy en día, la RSC o RSE está cada día más presente. Las empresas empiezan, además del estricto cumplimiento de la legislación vigente, a adoptar diferentes compromisos con sus grupos de interés a partir del conocimiento de sus preocupaciones sociales y del respeto por los derechos humanos, laborales y medioambientales con el fin de ser transparentes y conscientes de la responsabilidad que sus acciones en sus actividades empresariales y productivas puedan tener en el resto de la sociedad.
Bibliografía
BETELGEUX-CHRISTEYNS. Informe de Responsabilidad Social Empresarial 2020. https://www.betelgeux.es/images/files/Catalogos/IRSE-BETELGEUX-CHRISTEYNS-2020.pdf. (Consultado 15 de febrero de 2020).
EUR-Lex. Estrategia renovada de la UE para 2011-2014 sobre la responsabilidad social de las empresas. https://eur-lex.europa.eu/legal-content/ES/ALL/?uri=CELEX%3A52011DC0681. (Consultado el 10 de febrero de 2020).
EUR-Lex. Libro Verde relativo a la responsabilidad social de las empresas. https://eur-lex.europa.eu/legal-content/ES/TXT/?uri=LEGISSUM:n26039. (Consultado 9 de febrero de 2020).
Eurostat (2019). Circular economy. Overview. https://ec.europa.eu/ eurostat/web/circular-economy. (Consultado 5 de febrero de 2020)
FIAB. Informe económico 2019. https://fiab.es/es/archivos/documentos/INFECO_2019.pdf. (Consultado 8 de febrero de 2020).
Fundación Economía Circular. Concepto Multi “R” de la economía circular. https://economiacircular.org/wp/. (Consultado 5 de febrero de 2020).
Fundación Ellen MacArthur. Hacia una economía circular: Motivos económicos para una transición acelerada. https://www.ellenmacarthurfoundation.org/assets/downloads/publications/Executive_summary_SP.pdf. (Consultado 9 de febrero de 2020).
Priede, T., Hilliard, I. (2019). La economía circular en la industria alimentaria. https://ecosfron.org/wp-content/uploads/Dossieres-EsF-35-RSC-en-la-industria-alimentaria.pdf. (Consultado 5 de febrero de 2020).
Puigdueta, I., Sanz, A., Aguilera E., López, L. (2019) Bartolomé y otros. Percepciones sobre la carne que nos hacen subestimar su impacto en el cambio climático. https://theconversation.com/percepciones-sobre-la-carne-que-nos-hacen-subestimar-su-impacto-en-el-cambio-climatico-110634. (Consultado 10 de febrero de 2020).
UN. Objetivos de desarrollo sostenible.
https://www.un.org/sustainabledevelopment/es/objetivos-de-desarrollo-sostenible/ (Consultado el 12 de febrero de 2020).
Vicky Foods. Memoria de Responsabilidad Social Corporativa 2019. https://vickyfoods.es/pdf/memoria-rsc-2019-vicky-foods.pdf. (Consultado 11 de enero de 2020).
Authors